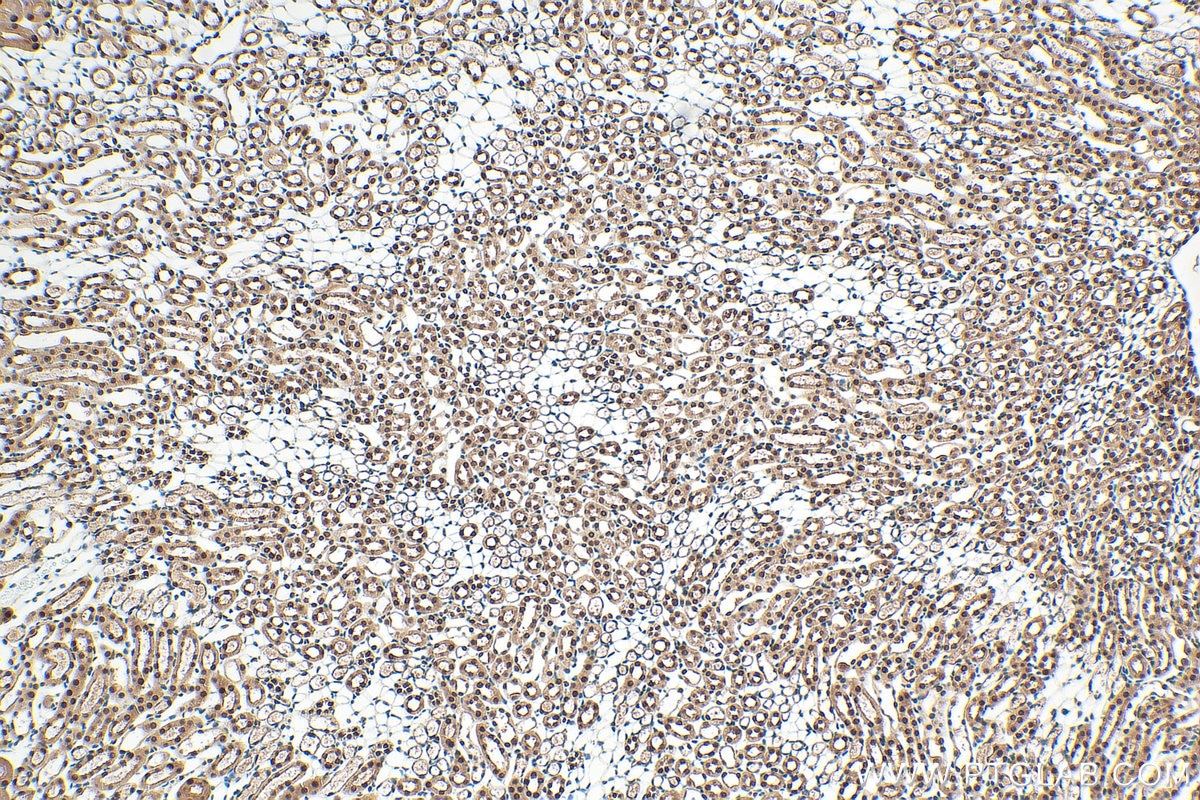
Immunohistochemistry (IHC) staining of mouse kidney tissue using SET/TAF-I Polyclonal antibody (55201-1-AP)

Tested Applications
| Positive WB detected in | HEK-293T cells, HeLa cells, HepG2 cells, Jurkat cells, NIH/3T3 cells |
| Positive IHC detected in | human liver cancer tissue, mouse kidney tissue Note: suggested antigen retrieval with TE buffer pH 9.0; (*) Alternatively, antigen retrieval may be performed with citrate buffer pH 6.0 |
Recommended dilution
| Application | Dilution |
|---|---|
| Western Blot (WB) | WB : 1:500-1:2000 |
| Immunohistochemistry (IHC) | IHC : 1:400-1:1600 |
| It is recommended that this reagent should be titrated in each testing system to obtain optimal results. | |
| Sample-dependent, Check data in validation data gallery. | |
Published Applications
| KD/KO | See 3 publications below |
| WB | See 17 publications below |
| IHC | See 3 publications below |
| IF | See 1 publications below |
Product Information
55201-1-AP targets SET/TAF-I in WB, IHC, IF, ELISA applications and shows reactivity with human, mouse samples.
| Tested Reactivity | human, mouse |
| Cited Reactivity | human, mouse |
| Host / Isotype | Rabbit / IgG |
| Class | Polyclonal |
| Type | Antibody |
| Immunogen |
Peptide Predict reactive species |
| Full Name | SET nuclear oncogene |
| Calculated Molecular Weight | 33 kDa |
| Observed Molecular Weight | 41 kDa, 39 kDa |
| GenBank Accession Number | NM_003011 |
| Gene Symbol | SET |
| Gene ID (NCBI) | 6418 |
| RRID | AB_10837360 |
| Conjugate | Unconjugated |
| Form | Liquid |
| Purification Method | Antigen affinity purification |
| UNIPROT ID | Q01105 |
| Storage Buffer | PBS with 0.02% sodium azide and 50% glycerol, pH 7.3. |
| Storage Conditions | Store at -20°C. Stable for one year after shipment. Aliquoting is unnecessary for -20oC storage. 20ul sizes contain 0.1% BSA. |
Background Information
SET, also named as IGAAD, I-2PP2A, TAF-I, IGAAD and PHAPII, belongs to the nucleosome assembly protein (NAP) family.SET is a multifunctional oncoprotein which is ubiquitously expressed in all kinds of cells. The SET protein participates in many cellular processes including cell cycle, cell migration, apoptosis, transcription, and DNA repair. The SET protein plays important roles in facilitating cell growth and proliferation via many pathways that promote tumorigenesis and metastasis. The SET protein shows apparent molecular masses of 41 and 39 kDa (PMID: 12759364, PMID: 7753797).
Protocols
| Product Specific Protocols | |
|---|---|
| IHC protocol for SET/TAF-I antibody 55201-1-AP | Download protocol |
| WB protocol for SET/TAF-I antibody 55201-1-AP | Download protocol |
| Standard Protocols | |
|---|---|
| Click here to view our Standard Protocols |
Publications
| Species | Application | Title |
|---|---|---|
Cell Rep A p53/LINC00324 positive feedback loop suppresses tumor growth by counteracting SET-mediated transcriptional repression
| ||
Oncotarget Overexpression of PP2A inhibitor SET oncoprotein is associated with tumor progression and poor prognosis in human non-small cell lung cancer.
| ||
J Med Chem Selective Peptidomimetic Inhibitors of NTMT1/2: Rational Design, Synthesis, Characterization, and Crystallographic Studies. | ||
Cancers (Basel) Pre-Clinical Study Evaluating Novel Protein Phosphatase 2A Activators as Therapeutics for Neuroblastoma. | ||
BMC Cancer MicroRNA-1915-3p inhibits cell migration and invasion by targeting SET in non-small-cell lung cancer. |